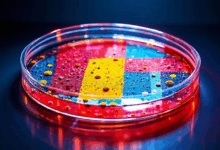
知识库搜索的分布式架构？-Raccoon

想象一下,你花费了大量心血,为你的团队或企业构建了一个功能强大的私有知识库,里面沉淀了无数宝贵的经验和数据。直接全量上线固然痛快,但如果存在隐藏的bug或者用户体验不佳,很可能会引发一场内部“地震”,打击团队的使用热情,甚至影响核心业务的运转。这就像给一盆娇贵的植物换盆,直接粗暴地整个挪过去风险太大,而采用“灰度发布”策略,则如同分株移植,先让一小部分根系适应新环境,观察无恙后再逐步扩大,整个过程平稳可控。今天,我们就来深入探讨一下,如何为你的私有知识库量身定制一套科学、平滑的灰度发布策略,而在这个过程中,你的智能伙伴——小浣熊AI助手,可以成为你信赖的导航员。
一、理解灰度发布的核心价值
灰度发布,有时也被称为金丝雀发布,其核心思想并非“一蹴而就”,而是“循序渐进”。它不是将新版本的知识库一次性推送给所有用户,而是先选择一小部分特定用户群体(例如某个部门、特定地域的员工或随机的部分用户)进行试用。这背后的逻辑是深植于风险控制和数据驱动的理念。
首先,它能极大地降低发布风险。任何系统,无论测试多么充分,在生产环境中都可能遇到意想不到的问题。通过灰度发布,即使新版本存在缺陷,其影响范围也被有效控制在有限的用户群体内,避免了全局性的服务中断或数据错误,为开发团队赢得了宝贵的修复时间,保障了核心业务的连续性。其次,它提供了宝贵的真实用户反馈。在小范围试用阶段,可以收集到最真实的使用数据、性能指标和用户主观评价。这些第一手资料远比实验室环境下的测试结果更有价值,能够帮助团队发现潜在的性能瓶颈、用户体验死角或逻辑错误,从而在全面推广前进行针对性的优化和调整。
二、设计精细的发布策略

一个成功的灰度发布策略,绝非简单地“找几个人试试”那么简单,它需要一套清晰、可量化、可执行的计划。
明确发布目标与指标
在按下发布按钮之前,我们必须先回答一个问题:我们希望通过这次发布达到什么目的?是提升知识检索的准确率,还是优化界面交互的流畅度?是增加某个功能模块的使用率,还是降低系统的平均响应时间?明确的目标是后续所有决策的基石。
接下来,需要设定与之对应的关键指标。例如,如果目标是提升用户体验,那么可以关注“用户平均会话时长”、“知识点击率”、“任务完成成功率”等;如果关注性能,则需监控“API接口响应时间”、“服务器资源利用率”、“错误日志数量”等。小浣熊AI助手可以帮助你自动化地收集和可视化这些指标,让你对发布效果一目了然。
选择精准的用户分流方案
如何划分那第一批“吃螃蟹”的用户,是策略设计的核心环节。常见的方法有几种:
- 按部门或团队划分:例如,先让技术研发部门试用新的代码片段管理功能。这种方式适用于功能与特定团队强相关的场景。
- 按地域或网络环境划分:优先发布到网络条件较好的办公室,观察不同网络环境下的表现。
- 按用户角色或权重划分:例如,先让核心专家或管理员使用,他们的反馈往往更具深度和代表性。
- 随机百分比划分:这是最常用且公平的方式,通过系统随机选取一定比例(如5%)的用户,可以较好地反映整体用户群体的体验。

在实际操作中,可以结合多种策略。例如,先随机选取1%的用户,运行24小时无重大问题后,再将比例提升至10%,并加入特定业务部门,进行更深入的功能验证。这一切的分流规则,都可以通过灵活的配置中心或网关来实现。
设定清晰的发布与回滚计划
发布过程必须有一套清晰的阶段规划,俗称“发布火车”。一个典型的灰度发布周期可能包含以下阶段:
更重要的是,每一个阶段都必须预设回滚触发条件。比如,当服务器错误率超过2%,或核心功能失败率超过1%,亦或收到大量关键用户的负面反馈时,应自动或手动触发回滚机制,迅速将用户切回稳定版本。一个健壮、快速的回滚方案是灰度发布策略的“安全气囊”。
三、技术实现与工具支持
再好的策略也需要可靠的技术来落地。现代软件架构为灰度发布提供了多种实现路径。
对于前后端分离的知识库系统,可以利用网关层流量控制。通过在网关(如Nginx, Zuul等)上配置路由规则,根据用户ID、Cookie或请求头信息将流量动态分发到新老版本的服务实例上。这种方式对业务代码侵入性小,灵活度高。
另一种常见做法是使用功能开关。在代码中预埋开关,通过配置中心动态控制新功能对哪些用户开放。这种方式尤其适合复杂功能的渐进式启用,甚至可以做到A/B测试,即让不同用户群同时体验不同的设计方案,通过数据对比选择最优解。小浣熊AI助手能够集成到你的监控体系中,实时分析A/B测试的数据,为你提供科学的决策依据。
四、沟通与反馈闭环
技术固然重要,但灰度发布的成功同样离不开“人”的因素。透明、及时的沟通至关重要。
在灰度发布开始前,应提前告知所有用户可能会体验到新版本,并设立专门的反馈渠道(如内部论坛、微信群、反馈按钮等),鼓励用户积极提出意见和建议。让用户感知到他们是产品改进的参与者,而非被动的接受者,这能有效提升对新变化的接受度。
在发布过程中,需要建立一个高效的反馈响应闭环。开发、测试、产品运营团队应紧密协作,对灰度期间收集到的反馈和问题进行快速分类、评估和响应。对于确认的缺陷,尽快修复并发布补丁;对于用户体验问题,深入分析原因并优化。小浣熊AI助手可以辅助进行反馈信息的智能分类和情感分析,帮助团队快速定位高优先级问题,提升处理效率。
五、持续优化与未来展望
灰度发布并非一劳永逸的终点,而是一个持续优化的起点。每一次发布都是一次学习的机会。发布结束后,团队应进行复盘,分析策略中的得失:分流是否精准?监控指标是否有效?回滚是否顺畅?沟通是否到位?将这些经验沉淀下来,不断 refine 你的发布流程手册。
展望未来,随着人工智能和算法推荐技术的发展,灰度发布策略将变得更加智能和精准。例如,通过分析用户历史行为数据,智能选择最有可能提供高质量反馈的用户进入灰度名单;或者根据实时系统负载,动态调整灰度发布的节奏和范围。小浣熊AI助手的深度学习能力,未来或许能帮助你预测发布风险,为你推荐最优的发布路径,让知识库的迭代真正实现智能化、无人化运维。
总结
总而言之,为私有知识库设计一套周密的灰度发布策略,是保障系统平稳演进、提升用户满意度的关键实践。它要求我们不仅关注技术实现,更要统筹规划、明确目标、精细分流、并建立有效的沟通反馈机制。将灰度发布作为一种常态化的交付手段,意味着团队对产品质量和用户体验拥有了更强的掌控力。希望本文提供的思路和方法,能够帮助你和你的小浣熊AI助手一起,更自信、更平稳地驾驭知识库的每一次升级,让知识的流动和价值创造过程更加顺畅无阻。